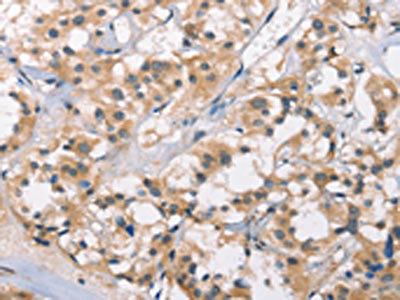

DGAT1 Antibody
-
中文名稱:DGAT1兔多克隆抗體
-
貨號:CSB-PA794725
-
規格:¥1100
-
圖片:
-
The image on the left is immunohistochemistry of paraffin-embedded Human gastic cancer tissue using CSB-PA794725(DGAT1 Antibody) at dilution 1/40, on the right is treated with synthetic peptide. (Original magnification: ×200)
-
The image on the left is immunohistochemistry of paraffin-embedded Human thyroid cancer tissue using CSB-PA794725(DGAT1 Antibody) at dilution 1/40, on the right is treated with synthetic peptide. (Original magnification: ×200)
-
-
其他:
產品詳情
-
Uniprot No.:
-
基因名:DGAT1
-
別名:DGAT1; AGRP1; DGAT; Diacylglycerol O-acyltransferase 1; ACAT-related gene product 1; Acyl-CoA retinol O-fatty-acyltransferase; ARAT; Retinol O-fatty-acyltransferase; Diglyceride acyltransferase
-
宿主:Rabbit
-
反應種屬:Human,Mouse,Rat
-
免疫原:Synthetic peptide of Human DGAT1
-
免疫原種屬:Homo sapiens (Human)
-
標記方式:Non-conjugated
-
抗體亞型:IgG
-
純化方式:Antigen affinity purification
-
濃度:It differs from different batches. Please contact us to confirm it.
-
保存緩沖液:-20°C, pH7.4 PBS, 0.05% NaN3, 40% Glycerol
-
產品提供形式:Liquid
-
應用范圍:ELISA,IHC
-
推薦稀釋比:
Application Recommended Dilution ELISA 1:1000-1:2000 IHC 1:25-1:100 -
Protocols:
-
儲存條件:Upon receipt, store at -20°C or -80°C. Avoid repeated freeze.
-
貨期:Basically, we can dispatch the products out in 1-3 working days after receiving your orders. Delivery time maybe differs from different purchasing way or location, please kindly consult your local distributors for specific delivery time.
-
用途:For Research Use Only. Not for use in diagnostic or therapeutic procedures.
相關產品
靶點詳情
-
功能:Catalyzes the terminal and only committed step in triacylglycerol synthesis by using diacylglycerol and fatty acyl CoA as substrates. Highly expressed in epithelial cells of the small intestine and its activity is essential for the absorption of dietary fats. In liver, plays a role in esterifying exogenous fatty acids to glycerol, and is required to synthesize fat for storage. Also present in female mammary glands, where it produces fat in the milk. May be involved in VLDL (very low density lipoprotein) assembly. In contrast to DGAT2 it is not essential for survival. Functions as the major acyl-CoA retinol acyltransferase (ARAT) in the skin, where it acts to maintain retinoid homeostasis and prevent retinoid toxicity leading to skin and hair disorders. Exhibits additional acyltransferase activities, includin acyl CoA:monoacylglycerol acyltransferase (MGAT), wax monoester and wax diester synthases. Also able to use 1-monoalkylglycerol (1-MAkG) as an acyl acceptor for the synthesis of monoalkyl-monoacylglycerol (MAMAG).
-
基因功能參考文獻:
- Study identified a large cohort of patients with congenital diarrheal disorders with mutations in DGAT1 that reduced expression of its product; dermal fibroblasts and intestinal organoids derived from these patients had altered lipid metabolism and were susceptible to lipid-induced cell death. Expression of full-length wildtype DGAT1 or DGAT2 restored normal lipid metabolism in these cells. PMID: 29604290
- our findings indicate that inhibition of both DGAT1 and ABHD5 using siRNA leads to reduction in prostate cancer cell growth. PMID: 28877685
- data reveal an important role for DGAT activity and TG synthesis generally in averting ER stress and lipotoxicity, with specifically DGAT1 performing this function during stimulated lipolysis in adipocytes. PMID: 28768178
- DGAT1 mutations result in a spectrum of diseases PMID: 28373485
- A novel homozygous missense variant was identified in a family with protein losing enteropathy. A splice site mutation in intron 8 was identified in a second family with PLE. These cases of DGAT1 deficiency extend the molecular and phenotypic spectrum of PLE. PMID: 26883093
- DGAT1 expression is down-regulated in viral hepatitis-related cirrhosis. PMID: 26493024
- Data indicate no clinically relevant pharmacokinetic interaction between DGAT-1 inhibitor pradigastat and rosuvastatin. PMID: 25740267
- the apparent lack of therapeutic window owing to GI side effects of AZD7687, particularly diarrhoea, makes the utility of DGAT1 inhibition as a novel treatment for diabetes and obesity questionable. PMID: 24118885
- Downregulation of CLDN1 was associated with altered fatty acid homeostasis in the absence of DGAT1. PMID: 24899196
- MGAT2 functions as a dimeric or tetrameric protein and selectively heterodimerizes with DGAT1 in mammalian cells PMID: 24573674
- The structure-activity relationship studies of a novel series of carboxylic acid derivatives of pyridine-carboxamides as DGAT-1 inhibitors is described. PMID: 23317570
- adipose overexpression of Dgat1 gene in transgenic mice leads to diet-inducible insulin resistance. PMID: 16306352
- Diacylglycerol acyltransferase-1 localizes hepatitis C virus NS5A protein to lipid droplets and enhances NS5A interaction with the viral capsid core PMID: 23420847
- results identify DGAT1 loss-of-function mutations as a rare cause of congenital diarrheal disorders PMID: 23114594
- describe distinct but synergistic roles of the two DGATs in an integrated pathway of TAG synthesis and secretion, with DGAT2 acting upstream of DGAT1 PMID: 22748069
- a comprehensive evaluation of a small molecule inhibitor for DGAT1 and suggests that pharmacological inhibition of DGAT1 holds promise in treating diverse metabolic disorders. PMID: 21990351
- DGAT1 belongs to the family of oligomeric membrane proteins that adopt a dual membrane topology. PMID: 21846726
- human small intestinal DGAT, which is mainly encoded by DGAT1, utilizes 1,2-DAG as the substrate to form TAG PMID: 21369919
- The triglyceride-synthesizing enzyme diacylglycerol acyltransferase-1 (DGAT1) is identified as a key host factor for hepatitis C virus infection. PMID: 20935628
- Identify DGAT1 as an important protein that participates in the effect of HNF4A on hepatic secretion of triglyceride-rich lipoproteins. PMID: 20167659
- Polymorphism associated with alterations in body mass index, high density lipoprotein levels and blood pressure in Turkish women. PMID: 12123490
- DGAT1 overexpression in murine white adipose tissue provides a model in which obesity does not impair glucose disposal PMID: 12401709
- DGAT participates in the regulation of membrane lipid synthesis and lipid signaling, thereby playing an important role in modulating cell growth properties PMID: 14557275
- Niacin selectively inhibited DGAT2 but not DGAT1 activity, but had no effect on the expression of DGAT1 and DGAT2 mRNA PMID: 15258194
- thiazolidinediones upregulate the adipocyte lipid storage genes DGAT and FAS but have no significant effect on LPL PMID: 16894240
- Review summarizes current knowledge of DGAT1 and DGAT2 enzymes, focusing on new advances since the cloning of their genes, including possible roles in human health and diseases. PMID: 18757836
- the acylation of acylglycerols by DGAT1 is important for dietary fat absorption in the intestine PMID: 18768481
- Report visceral and subcutaneous adipose tissue diacylglycerol acyltransferase activity in humans. PMID: 19197254
顯示更多
收起更多
-
相關疾病:Diarrhea 7 (DIAR7)
-
亞細胞定位:Endoplasmic reticulum membrane; Multi-pass membrane protein.
-
蛋白家族:Membrane-bound acyltransferase family, Sterol o-acyltransferase subfamily
-
數據庫鏈接:
Most popular with customers
-
-
YWHAB Recombinant Monoclonal Antibody
Applications: ELISA, WB, IHC, IF, FC
Species Reactivity: Human, Mouse, Rat
-
Phospho-YAP1 (S127) Recombinant Monoclonal Antibody
Applications: ELISA, WB, IHC
Species Reactivity: Human
-
-
-
-
-